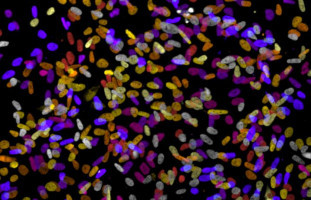
La pérdida de células caliciformes intestinales causa una enfermedad mortal después del trasplante de células madre

El trasplante de células madre alogénicas puede causar una pérdida de células caliciformes protectoras del revestimiento interno del colon, lo que puede ser fatal.
Pero potenciar esas células de antemano podría mejorar el resultado.
Una pérdida significativa de las células del colon después de un trasplante de células madre conduce a la invasión bacteriana de la mucosa intestinal, afectando el pronóstico del receptor.
Una inyección con un factor de crecimiento de células caliciformes antes del trasplante podría mejorar el resultado.
Este hallazgo, realizado por investigadores y colegas de la Universidad de Hokkaido, fue publicado en la revista Science Translational Medicine.
El trasplante de células madre hematopoyéticas alogénicas implica la transferencia del sistema inmunológico y hematopoyético de un donante sano al receptor para tratar trastornos hematológicos como la leucemia y el linfoma.
Sin embargo, algunos pacientes desarrollan una enfermedad mediada por la inmunidad del donante conocida como enfermedad de injerto contra huésped después del trasplante.
La enfermedad puede ser mortal en algunos casos, lo que limita el uso generalizado del tratamiento.
Los hematólogos de la Universidad de Hokkaido, Daigo Hashimoto, Takanori Teshima y sus colegas querían entender mejor lo que ocurre en el intestino durante la enfermedad de injerto contra huésped a nivel celular.
Mediante estudios en ratones, descubrieron que el trasplante de células madre hematopoyéticas alogénicas puede dar lugar a una reducción significativa de un tipo de célula epitelial en el revestimiento interior del colon llamada célula caliciforme.
Estas células producen la capa de mucosidad protectora que impide que las bacterias intestinales pasen al tejido intestinal y al torrente sanguíneo.
Los científicos descubrieron que la reducción de las células caliciformes maduras después del trasplante alteró la capa de moco que formaban, lo que provocó la invasión bacteriana del tejido intestinal.
Sin embargo, el número de células caliciformes aumentó significativamente en el colon después de que los científicos inyectaran a los ratones con interleucina-25 (IL-25), un factor de crecimiento para las células caliciformes, durante seis días antes del trasplante.
En los ratones con la inyección de IL-25, significativamente menos bacterias pudieron invadir la mucosa intestinal después del trasplante de células madre alogénicas.
Investigaciones posteriores revelaron que una molécula antimicrobiana llamada Lypd8, que es secretada por otro tipo de célula de colon y reside en la mucosa, se pierde en los ratones con la capa interna de mucosa alterada en la enfermedad de injerto contra huésped.
También encontraron que el Lypd8 es necesario para que la IL-25 tenga su efecto protector.
"Todo esto demuestra que las células caliciformes inhiben la invasión bacteriana manteniendo la capa de moco donde reside la molécula antimicrobiana", afirmaron los investigadores.
Los investigadores luego estudiaron biopsias de colon tomadas de pacientes humanos que habían recibido este tipo de transplante.
Las células caliciformes se dañaron específicamente en pacientes que desarrollaron la enfermedad de injerto contra huésped, y la pérdida severa de células caliciformes se asoció con una mala supervivencia después del trasplante.
"Encontramos que las células caliciformes intestinales mantienen la capa de moco que contiene moléculas antimicrobianas, evitando así la invasión de las bacterias intestinales. Por lo tanto, la administración de IL-25 para proteger las células caliciformes de los pacientes podría resultar una estrategia exitosa contra la enfermedad de injerto contra huésped después de un trasplante de células madre hematopoyéticas alogénicas", dijo Daigo Hashimoto.
"El recuento de células caliciformes mediante métodos no invasivos, como la endomicroscopia láser confocal, también podría utilizarse para el diagnóstico y la supervisión de la enfermedad del injerto contra el huésped", añadió Takanori Teshima.
Fuente: Universidad de Hokkaido
Somos una organización benéfica independiente y no estamos respaldados por una gran empresa o sociedad. Recaudamos cada centavo para elevar los estándares del cáncer a través de la educación. Puede ayudarnos a continuar nuestro trabajo para abordar las desigualdades en la atención del cáncer haciendo una donación.
Cualquier donación, por pequeña que sea, contribuye directamente a los costos de crear y compartir educación oncológica gratuita. Juntos podemos obtener mejores resultados para los pacientes abordando las desigualdades mundiales en el acceso a los resultados de la investigación del cáncer.
Gracias por tu apoyo.